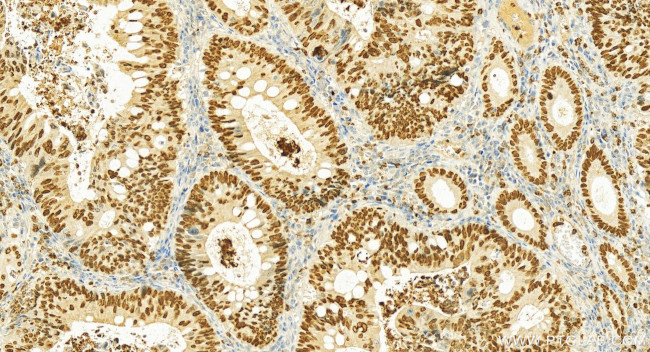
SATB2 Antibody in Immunohistochemistry (Paraffin) (IHC (P))

Search
Proteintech
SATB2 Polyclonal Antibody
{{$productOrderCtrl.translations['antibody.pdp.commerceCard.promotion.promotions']}}
{{$productOrderCtrl.translations['antibody.pdp.commerceCard.promotion.viewpromo']}}
{{$productOrderCtrl.translations['antibody.pdp.commerceCard.promotion.promocode']}}: {{promo.promoCode}} {{promo.promoTitle}} {{promo.promoDescription}}. {{$productOrderCtrl.translations['antibody.pdp.commerceCard.promotion.learnmore']}}
产品信息
19557-1-AP
种属反应
宿主/亚型
分类
类型
抗原
偶联物
形式
浓度
规格
纯化类型
保存液
内含物
保存条件
运输条件
靶标信息
DNA-binding protein SATB2 binds to DNA at the nuclear matrix- or scaffold associated regions. It is thought to recognize the sugar-phosphate structure of double-stranded DNA. SATB2 is a transcription factor controlling nuclear gene expression by binding to matrix attachment regions (MARs) of DNA and inducing a local chromatin-loop remodeling. It also acts as a docking site for several chromatin remodeling enzymes by recruiting corepressors (HDACs) or coactivators (HATs) directly to promoters and enhancers. SATB2 is required for the initiation of the upper-layer neurons (UL1) specific genetic program and for the inactivation of deep-layer neurons (DL) and UL2 specific genes - probably by modulating BCL11B expression. It is a repressor of Ctip2 and a regulatory determinant of corticocortical connections in the developing cerebral cortex. Mutations in the gene are associate with cleft palate isolated (CPI).
仅用于科研。不用于诊断过程。未经明确授权不得转售。
篇参考文献 (0)
生物信息学
蛋白别名: DNA-binding protein SATB2; FLJ21474; FLJ32076; KIAA1034-like DNA binding protein; MGC119474; MGC119477; SATB family member 2; SATB2 fusion; Special AT-rich sequence-binding protein 2; truncated protein after SATB2; two cut domains-containing homeodomain protein; unnamed protein product
基因别名: C2DELq32q33; DEL2Q32Q33; GLSS; KIAA1034; mKIAA1034; SATB2
UniProt ID: (Human) Q3ZB87, (Mouse) Q8VI24
Entrez Gene ID: (Human) 23314, (Mouse) 212712